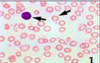
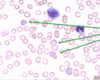

(5) Environmental Nutrition (Martin) Flashcards
(79 cards)
Generally, what trends have we observed in diseases that are increasing?
Cardiovascular disease
Cancer
HIV/AIDs and TB

Generally, what trends have we observed in diseases that are decreasing?
Neonatal conditions
Diarrhea
Lower respiratory infections

What are some negative impacts on human health suffered from climate change?
Air pollution/heatwaves –> Cardiovascular, cerebrovascular and respiratory dzs
Floods/disruption of clean water supplies –> Gastroenteritis, cholera & foodborne/waterborne infectious dzs
Disrupted crop production –> malnutrition
Increased temps, extreme weather –> Malaria, dengue fever
Pollutant:
Ozone
Populations at risk?
Healthy children
Healthy adults
Atheletes
Outdoor workers
Asthmatics
Pollutant:
Ozone
Effects on healthy adults/chilrden?
Decreased lung function
Increased airway reactivity
Lung inflammation
Pollutant:
Ozone
Effects on Athletes, outdoor workers, asthmatics?
Decreased exercise capacity
Increased hospitalizations
Pollutant:
Sulfur Dioxide
Populations at risk?
Healthy adults
Individuals with chronic lung disease
Asthmatics
Pollutant:
Sulfur Dioxide
Effect on healthy adults?
Increased respiratory symptoms
Pollutant:
Sulfur Dioxide
Effect on Individuals with chronic lung disease?
Increased mortality
Pollutant:
Sulfur Dioxide
Effect on Asthmatics?
Increased hospitalization
Decreased lung function
Why is particulate matter (soot) so dangerous to inhale?
*THEY ENTER THE ALVEOLI –> which causes the release of inflammatory mediators
Induces pulmonary inflammation and secondary CV effects
Fine or Ultrafine particles less than 10microm in diameter are the most harmful
What is the major hallmark for carbon monoxide poisoning?
Cherry red color of the skin and mucous membranes

Describe carbon monoxide’s characteristics as a gas
Nonirritating
Colorless
Tasteless
Odorless
What are some notable situations where a person is suceptible to chronic CO poisoning?
Working in tunnels
Underground garages
Highway toll booths
What are some notable situations where a person is suceptible to acute CO poisoning?
In small, closed garage w/ running car
Mine fires
How does CO poisoning ultimatley kill?
Kills by inducing CNS depression and widespread ischemic changes
What anatomic structures are affected by CO poisoning?
Basal ganglia
Lenticular nuclei
If your patient recovers from CO poisoning, what would you expect to be lasting effects?
Memory, vision, hearing and speech impairment
With 60-70% CO saturation, a person can die in as little as…
5 min
What is unique about a CO poisoned brain vs a normal brain?
CO posioned brain has increased detail in anatomical structures

What are examples of indoor air pollution?
- Wood smoke
- Bioaerosols (pet dander, fungi, molds)
- Radon
- Formaldehyde
- Sick building syndrome
Lead
What are it’s effects on the human body?
Hematologic
Skeletal
Neurologic
GI
Renal
TOXICITIES!!!!
Where is lead frequently found by children?
Flaking lead paint and soil
Where are common places for adults to encounter lead during occupational exposure?
Battery manufacturing
Pigments
Car radiators
Tin cans